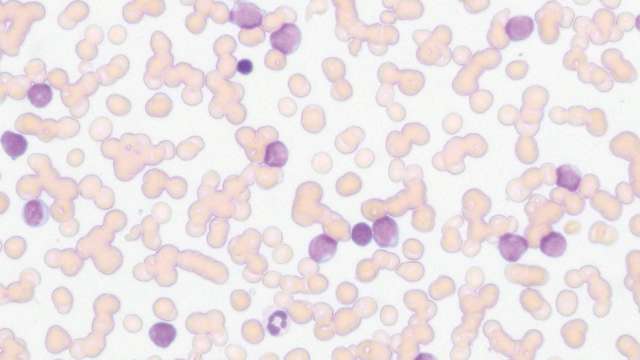

专注于舒适对焦
为了满足专业人士长时间使用显微镜的严格要求,尼康设计了ECLIPSE Si。
ECLIPSE Si采用可提高操作效率的人体工学设计。这款功能强大的显微镜可以减轻身体疲劳,有助于您持久保持专注度。
ECLIPSE Si已然成为显微镜行业的新标杆,拓展了探索微观世界的可能性。

Description
主要特性
追求高效的工作流程
ECLIPSE Si的设计初衷主要是为了减轻显微镜使用过程中产生的疲惫感。ECLIPSE Si消除了不必要的调整动作,使操作变得更加高效和舒适。即使是反复操作,其人体工学设计也有助于操作者始终保持自然姿态。

切换倍率时保持舒适的光亮度
倍率不同的物镜传递光量的程度也不同。因此,每次更换物镜时用户都要调整光强度。此外,从高倍率物镜切换至低倍率物镜时,亮度突然增加常会造成眼睛疲劳。ECLIPSE Si的光强度管理(LIM)功能可以自动记忆并再现每种物镜的光强度水平。LIM最多可减少40%光强度调节时间*。当日常工作中需要频繁更换不同倍率的物镜时,ECLIPSE Si既能提高用户使用的舒适性,又可以节省时间。
*与以往LED型号显微镜对比,更换三个物镜和调整光强度所需的时间(经尼康测试)

LIM功能关闭
由于亮度随物镜变化,切换倍率会引起眼睛疲劳。

使用高倍物镜

使用低倍物镜
LIM功能开启
自动再现调节好的光强度水平并应用在相应的物镜上,因此消除了切换倍率时光强度的突然变化,提高了工作流程效率。

使用高倍物镜
使用低倍物镜
低载物台,轻松更换载玻片
ECLIPSE Si的载物台高度为135 mm,比尼康传统显微镜的载物台高度降低了约50 mm。这种低载物台设计减少了更换标本载玻片需要的移动范围,从而能减轻手臂和肩部疲劳。由于载物台摇杆的位置较低,因此您可以将手搁在工作台上进行操作,并且能轻松观察标本载玻片上的不同区域。打开和关闭标本夹片的操作杆也采用了人体工学设计,具有方便操作的尺寸和形状。此外,为了优化载玻片更换,ECLIPSE Si的载物台比尼康传统显微镜的载物台小30%。


操作简单的标本夹片
在显微镜的整个工作流程中保持自然姿态
目镜筒的倾角为45度,使操作者在通过目镜进行观察时可以保持自然姿态。低载物台设计同时允许您从通过目镜观察流畅地切换到检查载玻片在载物台上的摆放位置而无需调整姿态。还能通过视平升高器可选配件进一步调整目镜高度。

视平升高器

检查载物台时保持观察姿态
聚焦时不必担心损坏载玻片或物镜
ECLIPSE Si配备载物台上限高度设定功能。即使在转动调焦旋钮时,载物台也能停在设定的高度上,从而消除了过调和损坏载玻片或物镜的风险。
用户可以放心地进行标本更换和调焦,再也不用担心载物台高度问题。

在您想要设定的高度上转动螺钉,就这么简单

载物台不会高过设定高度
追求轻松无忧的易用性
我们希望设计一款显微镜能够消除因频繁更换标本而产生的疲劳,并提供更舒适的用户体验。ECLIPSE Si将各种创新功能和智能设计结合在一起,最大程度地减少不必要的身体移动,在检视大量载玻片时为用户节省时间、减轻疲劳。
调焦和移动载物台均可单手完成
粗、细调焦旋钮位于显微镜两侧,左手或右手都能进行调焦。此外,载物台摇杆位置靠近调焦旋钮,用户用同一只手即可轻松完成载物台位置调整和调焦操作。因此,用户就能使用另一只手专门用来转动物镜转换器或更换载玻片。这些特点使检视大量试样载玻片时的工作流程的效率得以提高。


粗/细调焦和载物台移动均可单手操作
状态显示
照明亮度用液晶屏上的条形图表示。看一眼即可查看倍率,无需改变观察姿态。

❶Eco模式:已开启
❷LIM功能:已开启
❸物镜名称
❹倍率
❺光强状态
旋钮转动方向显示
可以直观地掌握对焦和光强控制旋钮的转动方向。

清楚了解要操作的摇杆
在载物台的前后和左右行程标尺上显示要操作的载物台摇杆图标。

舒适地改变倍率
反向逆装物镜转换器使物镜更易使用,并且便于看清使用中的物镜。在需要频繁改变倍率时,较低的物镜转换器位置能减轻手臂疲劳。物镜转换器有一个方便平滑旋转的环,最多可安装五个物镜,提供更宽泛的倍率选择。

轻松旋转五孔物镜转换器
遮挡LED光中的蓝光成分
LED光中含有大量蓝光或短波长光,因此存在长时间观察显微镜可能造成眼睛疲劳的担忧。ECLIPSE Si提供了可选的阻挡蓝光的滤光片配件,其可以置于视场透镜上,消除LED光的蓝光成分。

一段时间内无操作后自动关闭电源
ECLIPSE Si配备有ECO模式。在ECO模式下,如果一段时间内显微镜上没有任何操作,ECLIPSE Si将自动关闭照明。用户可以调节待机时长。ECLIPSE Si的ECO模式是您毫不费心的省电助手。

持续按住光强控制旋钮,进入ECO模式
轻松的现场和远程图像共享
通过将ECLIPSE Si(三目镜版)与数码相机进行配置,可采集标本图像用于存档或与他人实时共享
当ECLIPSESi配置了Digital Sight 1000显微镜相机(可选)时,标本图像可以在显示器上轻松显示,供多人同时观察和记录而无需使用电脑。此外,只需将该相机连接到平板电脑*,就能通过网络与远程或场外电脑和智能设备实时共享图像。
还可提供能可靠采集标本真彩色图像的DS-Fi3*高清晰度显微镜相机。
* 需要安装NIS-Elements L成像软件。

在一台显示器上同时观察和显示标本

与另一房间或远程的电脑实时共享图像
高级光学组件,打造高画质图像
作为一家历史悠久的显微镜制造商,尼康积累的先进光学技术是成功开发ECLIPSE Si的关键。令人自豪的是,尼康有能力满足对标本进行准确观察的需求。
出色的图像平整度和色差校正
ECLIPSE Si采用CFI E Plan系列物镜,就算在视场周边,也能采集平整、清晰的图像。该系列物镜是CFI60无限远校正光学系统的组成部分,兼具分辨率高和工作距离长的特点。

还支持用22mm视场观察
当配备了拥有22mm大视场的FOV22镜筒*和透镜时,ECLIPSE Si能提高临床观察效率。

*C-TB、C-TF、C-TT和C-TE2镜筒
具有恒定色温的长寿型LED
高强度白色LED光源的使用寿命可达60,000小时。即使改变亮度,色温也始终保持不变,因此图像颜色不会随倍率改变而改变。

整个视场范围内亮度一致
内置于照明系统中的特有的复眼透镜可在整个视场范围内提供均匀一致的亮度。

复眼透镜
遮挡来自视场之外的光线
为获得最佳观察和图像采集效果,可使用ECLIPSE Si配备的视场光阑限制照明范围。调整视场光阑能抑制闪烁和重影的出现,实现高对比度图像观察。荧光观察期间,还可以限制标本的光漂白范围。

转动视场光阑拨盘,直到照明范围覆盖视场。
兼容各种观察方法
配合可选的配件,除了明场观察之外,还可在ECLIPSE Si上实现各种观察方法。
明场观察
使用具备出色图像平整度和卓越色差校正性能的物镜,可在整个视场上获得照明亮度一致的高画质图像。

相差观察
将相差滑块插入聚光镜插槽并将GIF滤光片固定在视场透镜上,可以较高的对比度观察无色透明标本无需染料染色或标记。可提供10X/20X/40X/100X相差物镜。


❶ CFI DL 相差物镜
❷ 相差滑块
❸ GIF滤光片
❹ 对中目镜
暗场观察
将暗场滑块插入聚光镜插槽并使用斜照明,可以可视化被标本散射的光线。这种方法能有效观察未染色标本(如活细菌)和检查胶体颗粒。
CFI E Plan Achromat 4X物镜不可用于暗场观察。


暗场滑块
简易偏光观察
只要将起偏器固定在视场透镜上并将检偏器固定在目镜筒卡口内,就能进行简易偏光观察。偏光状态可通过转动起偏器调节。


简易偏光观察用起偏器和检偏器
透射荧光观察
尼康提出了独特的透射荧光照明法,无需连接专用的落射照明器和荧光观察设备就能轻松实现荧光观察。只需将EX滤光片滑块插入聚光镜插槽并将BA滤光片滑块插入物镜转换器插槽,就能对GFP(绿色荧光蛋白)标本或用荧光染料(如FITC和Alexa 488)染色的标本进行荧光观察。


透射荧光套件
可通过智能手机访问在线指南
如欲直接访问在线指南,请点击此处。

*二维码是DENSO WAVE INCORPORATED的注册商标。

重视易存放性
ECLIPSE Si还十分注重观察后的易存放性。其设计小巧易携,即使电源线也可轻松地收纳其中。
携带方便
较之以往的机型,ECLIPSE Si主体重量减轻了14%*。显微镜底座两侧的夹持器和后臂有利于安稳携带。此外,可用螺钉牢牢固定目镜,以防运输途中发生坠落。
* LED型号时
易于存放
通过拧松镜筒锁紧螺钉将镜筒向后翻转,即可减少所需的存放空间。镜筒设计为拧松螺钉也不会掉落。显微镜主体上的图示明确标注了旋转方向。
此外,在存放显微镜时,可将交流适配器放置于显微镜的背侧,电源线也可整齐盘绕。



可选配件
Digital Sight 1000显微镜相机
Digital Sight 1000配备200万像素CMOS图像传感器,能采集最高1920 x 1080像素的彩色图像和动画。无需使用电脑,只要将其和显示器*、鼠标连接,就能完成图像采集。

*通过HDMI线缆连接。

可以进行简单测量,包括两点之间的距离和面积
DS-Fi3显微镜相机
DS-Fi3配备590万像素CMOS图像传感器,能采集最高2880 x 2048像素的高分辨率彩色图像*。其出色的色彩重现能力使得采集的图像颜色能忠实还原在显微镜下观察到的图像颜色。其高灵敏度还使得DS-Fi3成为采集荧光图像的理想选择。

* 如要控制该相机,需要安装NIS-Elements L成像软件。
NIS-Elements L成像软件
将Digital Sight 1000或DS-Fi3与安装了NIS-Elements L的平板电脑连接,就能通过网络与其他电脑共享被观察的标本图像。该软件还包含各种测量和注释功能。

示教单元
允许两人使用同一台显微镜同时进行观察。可提供两种类型:面对面型和并排型。关注区可用内置LED指针指示。

视平升高器
将视平升高器安装在目镜筒下面,可以将眼点提高25 mm。观察者可根据自身情况调整目镜高度,便于以舒适的姿态进行观察。

最多可安装两个视平升高器(50 mm)。
Digital Sight 1000、DS-Fi3显微镜相机和NIS-Elements L成像软件不可应用于临床。
病理标本与成像制导的协作 大阪细胞病理学实验室病理学家Yasushi Nakamura(中村靖司)博士。




